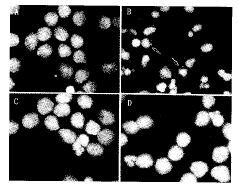

海洋甾体YC-1抑制低钾诱导大鼠小脑颗粒神经元的凋亡
作者:蔡翔 邱鹏新 苏兴文 李群 徐石海 颜光美
单位:中山医科大学药理教研室,广东 广州 510089
关键词:甾体;凋亡;神经元;钾;放线菌酮
中山医科大学学报000301
摘 要:【目的】观察海洋甾体YC-1对低钾(5 mmol/L,low K+)诱导小脑颗粒神经元凋亡的影响,并对其机制进行初步探讨。【方法】小脑颗粒神经元原代培养;采用二乙酸荧光素(fluorescein diacetate,FDA)和Hoechst 33258 DNA染色法观察神经元存活率及形态学特征;用琼脂糖凝胶电泳分析神经元死亡的生化特征。【结果】低钾引起小脑颗粒神经元凋亡。Hoechst 33258 DNA染色表现出染色体固缩,DNA凝胶电泳表现出由大小不一的断裂DNA片段形成的“梯形”条带。YC-1(1.25~20 μmol/L)呈时间和剂量依赖性地抑制上述现象的出现。蛋白质合成抑制剂放线菌酮(cycloheximide)不能改变由不同孵育时间造成的YC-1对神经元不同保护效果的差异。【结论】YC-1抑制低钾诱导小脑颗粒神经元凋亡,YC-1的这一作用可能属于一非基因效应。
, http://www.100md.com
中图分类号:R 961,966 文献标识码:A 文章编号:1000-257X(2000)03-0161-04
The Protection Effects of YC-1 on Cultured Rat Cerebellar Granule Neurons Against Apoptosis Induced by Low Potassium
CAI Xiang,QUI Peng-xin,SU Xing-wen,LI Qun,XU Shi-hai,YAN Guang-mei
(Department of Pharmacology Sun Yat-sen University of Medical Sciences,Guangzhou 510089,China)
Abstract:【Objective】To examine whether YC-1,a marine steroid,can rescue cultured rat cerebellar granule neurons from apoptosis induced by physiological concentration of potassium(5 mmol/L,low K+) and its mechanism.【Methods】Cerebellar granule neurons primarily were cultured.Neuronal viability and morphology were detected by fluorescein diacetate and Hoechst 33258.The biochemical features of neuronal death were characterized by agrose gel electrophoresis.【Results】The neuronal death induced by low K+ displayed the characteristics of apoptosis,including condensation of nuclear chromatin exhibited by Hoechst 33258 staining and DNA fragmentation visualized by agarose gel electrophoresis.Exposure of cultured cerebellar granule neurons to YC-1 results in dosage and time-dependent inhibition of apoptosis induced by low K+.Different neuronal protecting effects of YC-1 induced by different preteatment time of YC-1 cannot be abolished by cycloheximide,an inhibitor of protein synthesis.【Conclusion】YC-1 can block apoptosis of cerebellar granule neurons induced by low K+.The neuronal protection of YC-1 maybe belongs to a nongenomic action.
, 百拇医药
Key words:steroid;apoptosis;neurons;potassium;cycloheximide
传统理论认为,甾体激素首先与靶细胞胞(核)内的受体结合,再通过调节有关基因的表达而发挥作用。近年来,大量的实验证明,甾体激素对神经系统还具快速的调节作用,这一作用的发挥通常只需要数秒甚至更短的时间,提示这是一种非基因效应。有文献报道,甾体激素可通过与NMDA受体、GABAA等受体相互作用[1],通过调节胞内钙浓度[2],通过激动第二信使系统[3]以及通过激动丝裂源蛋白激酶[4]影响神经元的存活和早期神经系统的分化,而后两者又与一些神经营养因子,如神经生长因子(nerve growth factor,NGF)、脑源性神经营养因子(brain-derived neurotrophic fator,BDNF)、表皮生长因子(epidermal growth factor,EGF)影响神经元存活和分化有关。无血清、低钾培养基可诱导在体外培养的大鼠小脑颗粒神经元凋亡。升高细胞内钙浓度,激动第二信使系统以及一些神经营养因子可有效地抑制低钾诱导的小脑颗粒神经元调亡[5]。甾体激素对低钾诱导的神经元凋亡的作用未见报道。本文首次报道海洋甾体化合物YC-1可抑制低钾诱导的小脑颗粒神经元凋亡,并对其机制进行了初步探讨,希望能为新药开发以及为与凋亡相关的神经系统疾病的防治提供帮助。
, 百拇医药
1 材料与方法
1.1 材 料
YC-1由现工作于暨南大学化学系的徐石海教授提供,纯度为光谱纯;Basal Eagles Medium(BME)购于Gibgo(USA);Hoechst 33258购于Molecular probes(USA);其他药品购于Sigma(USA)。新生8 d Sprague-Dawley(SD)大鼠体质量15~20 g,雌雄兼用,由中山医科大学实验动物中心提供。
1.2 细胞培养
大鼠小脑颗粒神经元的培养参照文献[6],取第8天新生SD大鼠的小脑,经0.25 g/L胰酶消化后,加入0.5 g/L胰酶抑制剂和0.8 g/L DNase Ⅰ终止消化,离心(1 500 r/min, r=7.5 cm)5 min,弃上清液,将细胞加入含有100 mL/L胎牛血清和25 mmol/L KCl的BME中,以细胞为3.1×103/mm2接种于用Poly-L-lysine包被的35 mm2和24孔板的培养皿中,于体积分数为5%CO2的37 ℃培养箱中培养。接种后24 h加入10 μmol/L Ara-C以抑制胶质细胞的生长,使神经元的纯度为95%以上。
, 百拇医药
1.3 神经元存活率的测定
参照文献[6],取不给药或给药24 h后的神经元,去掉培养液,用含Ca2+,Mg2+的PBS洗1次,加入染活细胞的二乙酸荧光素FDA 10 mg/L(荧光下呈绿色)温育5 min用,PBS液洗细胞2次,荧光显微镜观察细胞的存活与死亡情况。在倒置荧光显微镜下,每个样本随机拍照4个低倍视野后,双盲法计活细胞数目,并按下列公式计算神经元的存活率(rate of neuronal survival):存活率=各组活细胞数/对照组活细胞×100%。
1.4 Hoechst 33258 DNA染色法
Hoechst 33258染色,参照文献[6],小脑颗粒神经元培养在35 mm2的培养皿中,第8天,分别给药24 h后移去培养基,PBS洗2次,40 g/L多聚甲醛液(4 ℃,溶在PBS中)固定10 min,蒸馏水洗2次,室温下待干。培养皿干后用Hoechst 33258(5 mg/L)染色5 min,用蒸馏水洗2次,室温下晾干。在荧光(Ex360 nm,Em 450 nm)显微镜下观察神经元形态学变化,并随机拍照。
, 百拇医药
1.5 琼脂糖凝胶电泳法
参照文献[6],将小脑颗粒细胞种植在35 mm2的培养皿中。第9天,即加入各药物24 h后,移去培养基,PBS洗2次,将收集的细胞离心(5 000 r/min,r=7.5 cm)5 min,细胞沉淀加入600 μL含10 mmol/L Tris-HCl,10 mmol/L EDTA和2 g/L Triton X-100(pH 7.5)的缓冲液中15 min,离心(12 000 r/min,r=7.5 cm)10 min。上清加等体积酚抽提1次,离心。上清再用等体积的酚、氯仿混合液抽提1次,离心。取上清,加入300 mmol/L的乙酸钠和等体积的异丙醇过夜。离心后用700 mL/L乙醇洗涤2~3次,干燥后加入TE(Tris 10 mmol/L;EDTA 1.0 mmol/L,pH7.4)和0.6 g/L的RNase A,37 ℃温育30 min,样品在15 g/L的琼脂糖凝胶上电泳1 h,溴乙淀染色后在紫外灯下观察拍照。
, 百拇医药
1.6 药物配制及给药方法
YC-1使用二甲基亚砜溶解,再用低钾培养基稀释,二甲基亚砜的终体积分数小于0.1%,实验对照组加入同等剂量的溶剂。其他药品均用低钾培养基配制。cycloheximide预孵育神经元90 min加入YC-1,换成低钾培养基的同时将cycloheximide洗掉,重新加入YC-1。
1.7 统计学分析处理
实验结果以
±s表示,采用student′s t检验。
2 结 果
2.1 YC-1对低钾诱导小脑颗粒神经元凋亡的影响
小脑颗粒神经元在体外培养的第8天弃去原培养基,换成低钾、无血清培养基,24 h后用相差显微镜观察,发现神经元胞体明显缩小,细胞核固缩。FDA荧光染色法分析表明,有80%左右的细胞凋亡。在换成低钾培养基之前或同时或之后的不同时间点给予YC-1(1.25~20 μmol/L),发现YC-1可剂量依赖性地抑制低钾诱导的小脑颗粒神经元凋亡,且与溶剂对照组相比,2.5 μmol(P<0.05),5 μmol、10 μmol、15 μmol、20 μmol(P<0.01)剂量点具有显著或极显著的统计学差异(见图1,图2)。
, 百拇医药
图1 给不同药物24 h后小脑颗粒神经元的细胞形态学观察
Fig.1 Morphological features of cerebellar granule neurons exposed to drugs for 24 h (×250)
A.Control;B.Low potassium;C.15 μmol/L YC-1 plus low potassium;D.15 μmol/L YC-1 (arrows indicate apoptoticneurons)
图2 YC-1剂量依赖性地抑制低钾诱导的小脑颗粒神经元凋亡
Fig.2 Dose-effect curves of YC-1 in the protection of
, 百拇医药
cerebellar granule neurons against apoptosis
induced by low potassium
2.2 细胞核形态学分析
Hoechst 33258染色显示,低钾24 h可使80%左右的小脑颗粒神经元凋亡
在换成低钾培养基的同时给予10 μmol/L YC-1组的细胞核染色质均匀分布,其形态接近对照组(图3)。
图3 Hoechst 33258 DNA染色分析细胞核形态
Fig.3 Nuclear analysis of apoptotic cells stained with
, http://www.100md.com
Hoechst 33258 (×400)
A.Control;B.Low potassium;C.10 μmol/L YC-1 plus low potassium;D.10 μmol/L YC-1(arrows indicate apoptotic neurons)
2.3 DNA的凝胶电泳分析
收集给药后24 h的细胞,按前文方法提取DNA,进行琼脂糖凝胶电泳。除了低钾组呈现明显的“阶梯状”条带外,其他组均未出现(图4)。
图4 断裂DNA片段的凝胶电泳
Fig.4 Agarose gel electrophoresis of DNA fragmentation
, http://www.100md.com
analysis
M.Marker;1.Control;2.Low potassium;3.10 μmol/L YC-1 plus low potassium;4.10 μmol/L YC-1
2.4 cycloheximide对YC-1作用的影响
10 μmol/L YC-1对低钾诱导的小脑颗粒神经元凋亡的抑制作用具有时间依赖性,随着孵育时间的延长,YC-1的抑制作用加强。用蛋白质合成抑制剂cycloheximide(1 mg/L)预孵育神经元90 min不能改变由孵育时间长短造成的YC-1对神经元的保护效果的差异(图5)。
图5 Cycloheximide对YC-1抑制低钾诱导的小脑颗粒神经元凋亡作用的影响
, 百拇医药
Fig.5 The effect of cycloheximide on the anti-apoptotic action of YC-1 against low potassium
3 讨 论
低钾诱导的小脑颗粒神经元凋亡模型被广泛应用于神经元凋亡机理的研究和防治与凋亡有关的神经系统疾病的新药开发中。低钾诱导的小脑颗粒神经元凋亡属于一种迟发性死亡,一些凋亡相关事件主要发生在低钾后2~5 h,包括c~jun、bax等基因(蛋白)的活化,细胞色素c的释放,caspases蛋白酶以及DNA酶的激活等。这些事件最终导致染色体固缩和DNA片段的形成[7]。实验证明,这一系列事件一旦启动完成,凋亡的发生将不可逆转。但在这之前增加胞内钙离子浓度、cAMP含量、激活丝裂源蛋白激酶等可抑制凋亡的发生。
当前,甾体激素与神经元存活关系的研究主要集中于甾体激素对神经元兴奋毒性死亡的影响。研究表明有些神经甾体可以作用于GABAA或NMDA等受体,从而加强或抑制一些兴奋性氨基酸(如glutamate、kainate)引起的神经元兴奋毒性死亡。我们发现YC-1可以取消由低钾造成的小脑颗粒神经元染色体固缩以及DNA片段的形成,证明YC-1可以有效地抑制低钾诱导的小脑颗粒神经元凋亡。
, 百拇医药
低剂量的NMDA受体激动剂具有神经保护作用[8]。但我们发现NMDA受体的特异性拮抗剂MK-801(10 μmol/L)、MEK1的特异性抑制剂PD98059(10 μmol/L)不能取消NC-1对低钾诱导的小脑颗粒神经元凋亡的抑制作用,提示上述途径不参与NC-1的这一作用(待发表)。除经典的基因组途径外,甾体激素在神经系统还发挥一种快速的效应,这一效应不需要基因的转录和表达。cycloheximide是蛋白质合成的特异性抑制剂,其本身可以抑制低钾诱导的小脑颗粒神经元调亡。为了避免cycloheximide的抗低钾作用,我们在低钾前将其洗掉,结果发现cycloheximide(1 μg/mL)对照组不能取消低钾诱导凋亡的作用,而且cycloheximide加YC-1(10 μmol/L)组仍可抑制低钾诱导的小脑颗粒神经元凋亡,且cycloheximide不能取消由孵育时间长短造成的YC-1保护神经元效果不同的差异,提示YC-1的这一作用不需要基因的表达,属于一种非基因效应。
基金项目:国家杰出青年基金(39625022),国家自然科学基金(39770851t,39870265),广东省自然科学基金(970094)
, 百拇医药
作者简介:蔡翔(1972-),男,陕西西安人,中山医科大学97级博士生,研究方向为神经药理学
颜光美,教授,博士导师,中国药理学会常务理事,美国神经科学学会会员,国家杰出青年基金获得者,研究方向为神经药理学.
参考文献:
[1]Paul S M,Purdy R H.Neuroactive steriod[J].FASEB Journal,1992,6(6):2311.
[2]Irwin R P,Lin S Z,Robert M A,et al.Steroid potentiation and inhibition of N-methyl-D-aspartate receptor-mediated intracellular Ca2+ responses:structure-activity studies[J].J Pharmacol Exp Ther,1994,271(2):677.
, http://www.100md.com
[3]Watters J J,Dorsa D M.Transcriptional effects of estrogen on neuronal neurotension gene expression involve cAMP/protein kinase A-dependent signaling mechanisms[J].J Neurosci,1998,8(17):6672.
[4]Singer C A,Figueroa-Masot X A,Barchelor R H,et al.The mitogen-activated protein kinase pathway mediates estrogen neuroprotection after glutamate toxicity in primary cortical neurons[J].J Neurosci,1999,19(7):2455.
[5]D′Mello S R,Galli C,Ciotti T,et al.Induction of apoptosis in cerebellar granule neurons by low potassium:inhibition of death by insulin-like growth factor I and cAMP[J].Proc Natl Acad Sci USA,1993,90(23):10989.
, 百拇医药
[6]Yan G M,Irwin R P,Lin S Z,et al.Diphenylhydantoin induces apoptotic cell death of cultured rat cerebellar granule neurons[J].J Pharmacol Exp Ther,1995,274(2):983.
[7]Ikeuchi T,Shimoke K,Kubo T,et al.Apoptosis-inducing and-preventing signal transduction pathways in cultured cerebellar granule neuron[J].Human cell,1998,11(3):125.
[8]Marini A M,Paul S M.N-Methyl-D-asparte receptor-mediated neuroprotection in cerebellar granul cells requires new RNA and protein synthesis[J].Proc Natl Acad Sci USA,1992,89(14):6555.
收稿日期:1999-12-28, 百拇医药
单位:中山医科大学药理教研室,广东 广州 510089
关键词:甾体;凋亡;神经元;钾;放线菌酮
中山医科大学学报000301
摘 要:【目的】观察海洋甾体YC-1对低钾(5 mmol/L,low K+)诱导小脑颗粒神经元凋亡的影响,并对其机制进行初步探讨。【方法】小脑颗粒神经元原代培养;采用二乙酸荧光素(fluorescein diacetate,FDA)和Hoechst 33258 DNA染色法观察神经元存活率及形态学特征;用琼脂糖凝胶电泳分析神经元死亡的生化特征。【结果】低钾引起小脑颗粒神经元凋亡。Hoechst 33258 DNA染色表现出染色体固缩,DNA凝胶电泳表现出由大小不一的断裂DNA片段形成的“梯形”条带。YC-1(1.25~20 μmol/L)呈时间和剂量依赖性地抑制上述现象的出现。蛋白质合成抑制剂放线菌酮(cycloheximide)不能改变由不同孵育时间造成的YC-1对神经元不同保护效果的差异。【结论】YC-1抑制低钾诱导小脑颗粒神经元凋亡,YC-1的这一作用可能属于一非基因效应。
, http://www.100md.com
中图分类号:R 961,966 文献标识码:A 文章编号:1000-257X(2000)03-0161-04
The Protection Effects of YC-1 on Cultured Rat Cerebellar Granule Neurons Against Apoptosis Induced by Low Potassium
CAI Xiang,QUI Peng-xin,SU Xing-wen,LI Qun,XU Shi-hai,YAN Guang-mei
(Department of Pharmacology Sun Yat-sen University of Medical Sciences,Guangzhou 510089,China)
Abstract:【Objective】To examine whether YC-1,a marine steroid,can rescue cultured rat cerebellar granule neurons from apoptosis induced by physiological concentration of potassium(5 mmol/L,low K+) and its mechanism.【Methods】Cerebellar granule neurons primarily were cultured.Neuronal viability and morphology were detected by fluorescein diacetate and Hoechst 33258.The biochemical features of neuronal death were characterized by agrose gel electrophoresis.【Results】The neuronal death induced by low K+ displayed the characteristics of apoptosis,including condensation of nuclear chromatin exhibited by Hoechst 33258 staining and DNA fragmentation visualized by agarose gel electrophoresis.Exposure of cultured cerebellar granule neurons to YC-1 results in dosage and time-dependent inhibition of apoptosis induced by low K+.Different neuronal protecting effects of YC-1 induced by different preteatment time of YC-1 cannot be abolished by cycloheximide,an inhibitor of protein synthesis.【Conclusion】YC-1 can block apoptosis of cerebellar granule neurons induced by low K+.The neuronal protection of YC-1 maybe belongs to a nongenomic action.
, 百拇医药
Key words:steroid;apoptosis;neurons;potassium;cycloheximide
传统理论认为,甾体激素首先与靶细胞胞(核)内的受体结合,再通过调节有关基因的表达而发挥作用。近年来,大量的实验证明,甾体激素对神经系统还具快速的调节作用,这一作用的发挥通常只需要数秒甚至更短的时间,提示这是一种非基因效应。有文献报道,甾体激素可通过与NMDA受体、GABAA等受体相互作用[1],通过调节胞内钙浓度[2],通过激动第二信使系统[3]以及通过激动丝裂源蛋白激酶[4]影响神经元的存活和早期神经系统的分化,而后两者又与一些神经营养因子,如神经生长因子(nerve growth factor,NGF)、脑源性神经营养因子(brain-derived neurotrophic fator,BDNF)、表皮生长因子(epidermal growth factor,EGF)影响神经元存活和分化有关。无血清、低钾培养基可诱导在体外培养的大鼠小脑颗粒神经元凋亡。升高细胞内钙浓度,激动第二信使系统以及一些神经营养因子可有效地抑制低钾诱导的小脑颗粒神经元调亡[5]。甾体激素对低钾诱导的神经元凋亡的作用未见报道。本文首次报道海洋甾体化合物YC-1可抑制低钾诱导的小脑颗粒神经元凋亡,并对其机制进行了初步探讨,希望能为新药开发以及为与凋亡相关的神经系统疾病的防治提供帮助。
, 百拇医药
1 材料与方法
1.1 材 料
YC-1由现工作于暨南大学化学系的徐石海教授提供,纯度为光谱纯;Basal Eagles Medium(BME)购于Gibgo(USA);Hoechst 33258购于Molecular probes(USA);其他药品购于Sigma(USA)。新生8 d Sprague-Dawley(SD)大鼠体质量15~20 g,雌雄兼用,由中山医科大学实验动物中心提供。
1.2 细胞培养
大鼠小脑颗粒神经元的培养参照文献[6],取第8天新生SD大鼠的小脑,经0.25 g/L胰酶消化后,加入0.5 g/L胰酶抑制剂和0.8 g/L DNase Ⅰ终止消化,离心(1 500 r/min, r=7.5 cm)5 min,弃上清液,将细胞加入含有100 mL/L胎牛血清和25 mmol/L KCl的BME中,以细胞为3.1×103/mm2接种于用Poly-L-lysine包被的35 mm2和24孔板的培养皿中,于体积分数为5%CO2的37 ℃培养箱中培养。接种后24 h加入10 μmol/L Ara-C以抑制胶质细胞的生长,使神经元的纯度为95%以上。
, 百拇医药
1.3 神经元存活率的测定
参照文献[6],取不给药或给药24 h后的神经元,去掉培养液,用含Ca2+,Mg2+的PBS洗1次,加入染活细胞的二乙酸荧光素FDA 10 mg/L(荧光下呈绿色)温育5 min用,PBS液洗细胞2次,荧光显微镜观察细胞的存活与死亡情况。在倒置荧光显微镜下,每个样本随机拍照4个低倍视野后,双盲法计活细胞数目,并按下列公式计算神经元的存活率(rate of neuronal survival):存活率=各组活细胞数/对照组活细胞×100%。
1.4 Hoechst 33258 DNA染色法
Hoechst 33258染色,参照文献[6],小脑颗粒神经元培养在35 mm2的培养皿中,第8天,分别给药24 h后移去培养基,PBS洗2次,40 g/L多聚甲醛液(4 ℃,溶在PBS中)固定10 min,蒸馏水洗2次,室温下待干。培养皿干后用Hoechst 33258(5 mg/L)染色5 min,用蒸馏水洗2次,室温下晾干。在荧光(Ex360 nm,Em 450 nm)显微镜下观察神经元形态学变化,并随机拍照。
, 百拇医药
1.5 琼脂糖凝胶电泳法
参照文献[6],将小脑颗粒细胞种植在35 mm2的培养皿中。第9天,即加入各药物24 h后,移去培养基,PBS洗2次,将收集的细胞离心(5 000 r/min,r=7.5 cm)5 min,细胞沉淀加入600 μL含10 mmol/L Tris-HCl,10 mmol/L EDTA和2 g/L Triton X-100(pH 7.5)的缓冲液中15 min,离心(12 000 r/min,r=7.5 cm)10 min。上清加等体积酚抽提1次,离心。上清再用等体积的酚、氯仿混合液抽提1次,离心。取上清,加入300 mmol/L的乙酸钠和等体积的异丙醇过夜。离心后用700 mL/L乙醇洗涤2~3次,干燥后加入TE(Tris 10 mmol/L;EDTA 1.0 mmol/L,pH7.4)和0.6 g/L的RNase A,37 ℃温育30 min,样品在15 g/L的琼脂糖凝胶上电泳1 h,溴乙淀染色后在紫外灯下观察拍照。
, 百拇医药
1.6 药物配制及给药方法
YC-1使用二甲基亚砜溶解,再用低钾培养基稀释,二甲基亚砜的终体积分数小于0.1%,实验对照组加入同等剂量的溶剂。其他药品均用低钾培养基配制。cycloheximide预孵育神经元90 min加入YC-1,换成低钾培养基的同时将cycloheximide洗掉,重新加入YC-1。
1.7 统计学分析处理
实验结果以
2 结 果
2.1 YC-1对低钾诱导小脑颗粒神经元凋亡的影响
小脑颗粒神经元在体外培养的第8天弃去原培养基,换成低钾、无血清培养基,24 h后用相差显微镜观察,发现神经元胞体明显缩小,细胞核固缩。FDA荧光染色法分析表明,有80%左右的细胞凋亡。在换成低钾培养基之前或同时或之后的不同时间点给予YC-1(1.25~20 μmol/L),发现YC-1可剂量依赖性地抑制低钾诱导的小脑颗粒神经元凋亡,且与溶剂对照组相比,2.5 μmol(P<0.05),5 μmol、10 μmol、15 μmol、20 μmol(P<0.01)剂量点具有显著或极显著的统计学差异(见图1,图2)。
, 百拇医药
图1 给不同药物24 h后小脑颗粒神经元的细胞形态学观察
Fig.1 Morphological features of cerebellar granule neurons exposed to drugs for 24 h (×250)
A.Control;B.Low potassium;C.15 μmol/L YC-1 plus low potassium;D.15 μmol/L YC-1 (arrows indicate apoptoticneurons)
图2 YC-1剂量依赖性地抑制低钾诱导的小脑颗粒神经元凋亡
Fig.2 Dose-effect curves of YC-1 in the protection of
, 百拇医药
cerebellar granule neurons against apoptosis
induced by low potassium
2.2 细胞核形态学分析
Hoechst 33258染色显示,低钾24 h可使80%左右的小脑颗粒神经元凋亡
在换成低钾培养基的同时给予10 μmol/L YC-1组的细胞核染色质均匀分布,其形态接近对照组(图3)。
图3 Hoechst 33258 DNA染色分析细胞核形态
Fig.3 Nuclear analysis of apoptotic cells stained with
, http://www.100md.com
Hoechst 33258 (×400)
A.Control;B.Low potassium;C.10 μmol/L YC-1 plus low potassium;D.10 μmol/L YC-1(arrows indicate apoptotic neurons)
2.3 DNA的凝胶电泳分析
收集给药后24 h的细胞,按前文方法提取DNA,进行琼脂糖凝胶电泳。除了低钾组呈现明显的“阶梯状”条带外,其他组均未出现(图4)。
图4 断裂DNA片段的凝胶电泳
Fig.4 Agarose gel electrophoresis of DNA fragmentation
, http://www.100md.com
analysis
M.Marker;1.Control;2.Low potassium;3.10 μmol/L YC-1 plus low potassium;4.10 μmol/L YC-1
2.4 cycloheximide对YC-1作用的影响
10 μmol/L YC-1对低钾诱导的小脑颗粒神经元凋亡的抑制作用具有时间依赖性,随着孵育时间的延长,YC-1的抑制作用加强。用蛋白质合成抑制剂cycloheximide(1 mg/L)预孵育神经元90 min不能改变由孵育时间长短造成的YC-1对神经元的保护效果的差异(图5)。
图5 Cycloheximide对YC-1抑制低钾诱导的小脑颗粒神经元凋亡作用的影响
, 百拇医药
Fig.5 The effect of cycloheximide on the anti-apoptotic action of YC-1 against low potassium
3 讨 论
低钾诱导的小脑颗粒神经元凋亡模型被广泛应用于神经元凋亡机理的研究和防治与凋亡有关的神经系统疾病的新药开发中。低钾诱导的小脑颗粒神经元凋亡属于一种迟发性死亡,一些凋亡相关事件主要发生在低钾后2~5 h,包括c~jun、bax等基因(蛋白)的活化,细胞色素c的释放,caspases蛋白酶以及DNA酶的激活等。这些事件最终导致染色体固缩和DNA片段的形成[7]。实验证明,这一系列事件一旦启动完成,凋亡的发生将不可逆转。但在这之前增加胞内钙离子浓度、cAMP含量、激活丝裂源蛋白激酶等可抑制凋亡的发生。
当前,甾体激素与神经元存活关系的研究主要集中于甾体激素对神经元兴奋毒性死亡的影响。研究表明有些神经甾体可以作用于GABAA或NMDA等受体,从而加强或抑制一些兴奋性氨基酸(如glutamate、kainate)引起的神经元兴奋毒性死亡。我们发现YC-1可以取消由低钾造成的小脑颗粒神经元染色体固缩以及DNA片段的形成,证明YC-1可以有效地抑制低钾诱导的小脑颗粒神经元凋亡。
, 百拇医药
低剂量的NMDA受体激动剂具有神经保护作用[8]。但我们发现NMDA受体的特异性拮抗剂MK-801(10 μmol/L)、MEK1的特异性抑制剂PD98059(10 μmol/L)不能取消NC-1对低钾诱导的小脑颗粒神经元凋亡的抑制作用,提示上述途径不参与NC-1的这一作用(待发表)。除经典的基因组途径外,甾体激素在神经系统还发挥一种快速的效应,这一效应不需要基因的转录和表达。cycloheximide是蛋白质合成的特异性抑制剂,其本身可以抑制低钾诱导的小脑颗粒神经元调亡。为了避免cycloheximide的抗低钾作用,我们在低钾前将其洗掉,结果发现cycloheximide(1 μg/mL)对照组不能取消低钾诱导凋亡的作用,而且cycloheximide加YC-1(10 μmol/L)组仍可抑制低钾诱导的小脑颗粒神经元凋亡,且cycloheximide不能取消由孵育时间长短造成的YC-1保护神经元效果不同的差异,提示YC-1的这一作用不需要基因的表达,属于一种非基因效应。
基金项目:国家杰出青年基金(39625022),国家自然科学基金(39770851t,39870265),广东省自然科学基金(970094)
, 百拇医药
作者简介:蔡翔(1972-),男,陕西西安人,中山医科大学97级博士生,研究方向为神经药理学
颜光美,教授,博士导师,中国药理学会常务理事,美国神经科学学会会员,国家杰出青年基金获得者,研究方向为神经药理学.
参考文献:
[1]Paul S M,Purdy R H.Neuroactive steriod[J].FASEB Journal,1992,6(6):2311.
[2]Irwin R P,Lin S Z,Robert M A,et al.Steroid potentiation and inhibition of N-methyl-D-aspartate receptor-mediated intracellular Ca2+ responses:structure-activity studies[J].J Pharmacol Exp Ther,1994,271(2):677.
, http://www.100md.com
[3]Watters J J,Dorsa D M.Transcriptional effects of estrogen on neuronal neurotension gene expression involve cAMP/protein kinase A-dependent signaling mechanisms[J].J Neurosci,1998,8(17):6672.
[4]Singer C A,Figueroa-Masot X A,Barchelor R H,et al.The mitogen-activated protein kinase pathway mediates estrogen neuroprotection after glutamate toxicity in primary cortical neurons[J].J Neurosci,1999,19(7):2455.
[5]D′Mello S R,Galli C,Ciotti T,et al.Induction of apoptosis in cerebellar granule neurons by low potassium:inhibition of death by insulin-like growth factor I and cAMP[J].Proc Natl Acad Sci USA,1993,90(23):10989.
, 百拇医药
[6]Yan G M,Irwin R P,Lin S Z,et al.Diphenylhydantoin induces apoptotic cell death of cultured rat cerebellar granule neurons[J].J Pharmacol Exp Ther,1995,274(2):983.
[7]Ikeuchi T,Shimoke K,Kubo T,et al.Apoptosis-inducing and-preventing signal transduction pathways in cultured cerebellar granule neuron[J].Human cell,1998,11(3):125.
[8]Marini A M,Paul S M.N-Methyl-D-asparte receptor-mediated neuroprotection in cerebellar granul cells requires new RNA and protein synthesis[J].Proc Natl Acad Sci USA,1992,89(14):6555.
收稿日期:1999-12-28, 百拇医药